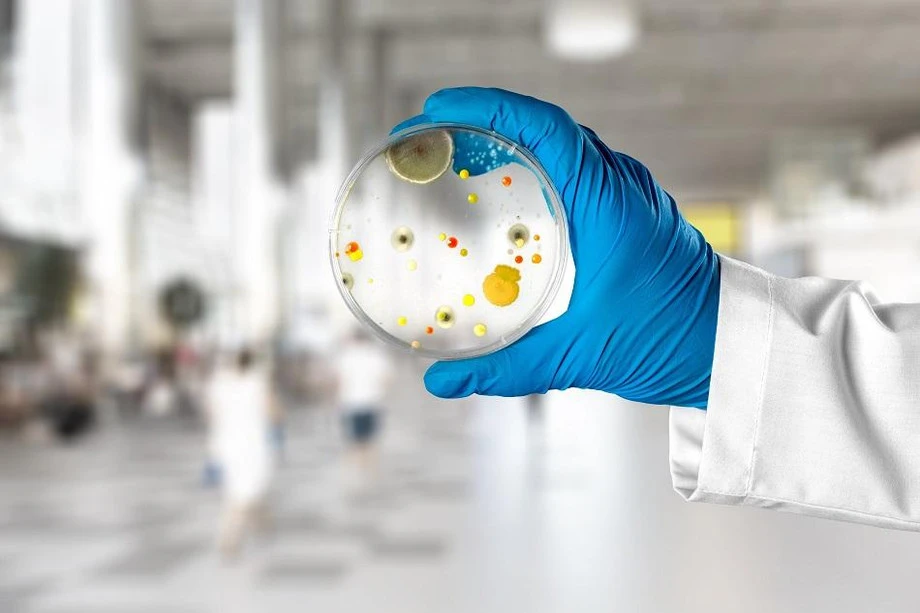

Introduction:
In the realm of biomedical research, the quest for understanding human diseases and developing effective treatments has led to the exploration of diverse methodologies and sample types. One crucial development in this field is the utilization of Formalin-Fixed Paraffin-Embedded (FFPE) human tissue samples. This innovative approach has gained significant traction in the United States, offering researchers a valuable resource to unravel the complexities of various diseases.
Understanding FFPE Tissue Samples:
FFPE refers to a preservation method where tissues are fixed in formaldehyde and embedded in paraffin wax, creating a stable and long-lasting repository of biological material. Historically, this technique has been a cornerstone in pathology for preserving tissue morphology on glass slides. However, in recent years, researchers have recognized the untapped potential of Human FFPE Tissue Sample in USA for molecular analysis.
Benefits of FFPE Tissue Samples:
- Archival Nature: One of the primary advantages of FFPE samples is their archival nature. Hospitals and research institutions routinely store FFPE blocks for extended periods, allowing retrospective studies and the investigation of diseases over time. This archival aspect is particularly valuable in studying chronic conditions or diseases with long incubation periods.
- Diverse Disease Applications: FFPE tissue samples have proven instrumental in studying a wide array of diseases, including cancers, neurological disorders, and infectious diseases. The availability of well-preserved tissue architecture enables researchers to examine molecular changes associated with diseases, offering insights into potential biomarkers and therapeutic targets.
- Large Sample Repositories: In the United States, numerous biobanks and research institutions have amassed substantial repositories of FFPE samples. These repositories provide researchers with access to a diverse range of tissues, facilitating large-scale studies and promoting collaboration across institutions.
- Cost-Effective Research: Utilizing FFPE samples can be more cost-effective than other tissue preservation methods. The ability to leverage existing archives eliminates the need for extensive prospective sample collection, reducing the overall cost of research projects. This affordability enhances the feasibility of studies, especially for researchers with limited budgets.
Challenges and Advances:
- DNA and RNA Degradation: FFPE samples often face challenges related to DNA and RNA degradation due to the fixation process. However, advancements in extraction techniques and the development of high-throughput sequencing technologies have mitigated these challenges. Researchers in the USA have successfully extracted high-quality genetic material from FFPE samples, allowing for comprehensive genomic analyses.
- Standardization of Protocols: Standardizing protocols for FFPE sample processing has been a major focus in the research community. The lack of uniformity in fixation and storage procedures can impact the quality of samples. Initiatives in the USA, such as the development of guidelines by research consortia, aim to establish standardized protocols to ensure reproducibility and reliability across studies.
- Integration with Clinical Data: To maximize the potential of FFPE samples, integration with clinical data is crucial. Efforts are underway in the USA to link biobanks and research databases, enabling researchers to correlate molecular findings with patient outcomes. This integrative approach enhances the clinical relevance of research findings and facilitates the translation of discoveries into personalized medicine.
Future Directions:
The future of utilizing FFPE tissue samples in the USA holds promising avenues for advancements in precision medicine and translational research. Several key areas warrant attention:
- Technological Innovations: Ongoing advancements in technology, such as single-cell sequencing and spatial transcriptomics, present exciting opportunities for enhancing the molecular analysis of FFPE samples. These innovations can provide a more nuanced understanding of cellular heterogeneity within tissues, contributing to personalized treatment strategies.
- Multi-Omics Approaches: Integrating multiple omics platforms, including genomics, transcriptomics, and proteomics, can offer a comprehensive view of molecular alterations in FFPE samples. Collaborative initiatives in the USA are exploring the feasibility of multi-omics analyses to unravel intricate disease mechanisms.
- Clinical Trial Biomarker Discovery: FFPE samples have the potential to play a pivotal role in identifying predictive biomarkers for response to therapies. Establishing robust associations between molecular signatures in FFPE samples and clinical outcomes can expedite the development of targeted therapies and inform patient stratification in clinical trials.
Conclusion:
As we celebrate the one-year anniversary of harnessing the potential of human FFPE tissue samples in the USA, it is evident that this approach has become a cornerstone in advancing biomedical research. The archival nature, diverse disease applications, and cost-effectiveness of FFPE samples make them invaluable resources for unraveling the intricacies of human diseases. With ongoing efforts to address challenges, standardize protocols, and integrate clinical data, the future holds exciting prospects for leveraging FFPE Block in USA in precision medicine and improving patient outcomes.
